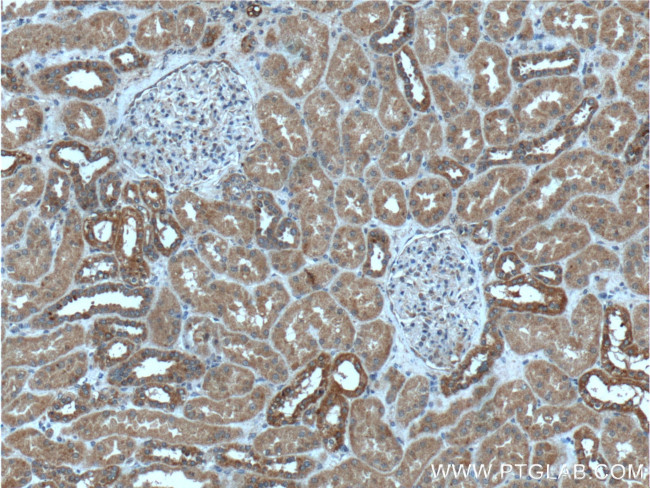
MAPK15 Antibody in Immunohistochemistry (Paraffin) (IHC (P))
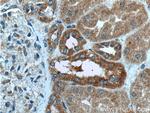
MAPK15 Antibody in Immunohistochemistry (Paraffin) (IHC (P))

Search
Proteintech
MAPK15 Polyclonal Antibody
{{$productOrderCtrl.translations['antibody.pdp.commerceCard.promotion.promotions']}}
{{$productOrderCtrl.translations['antibody.pdp.commerceCard.promotion.viewpromo']}}
{{$productOrderCtrl.translations['antibody.pdp.commerceCard.promotion.promocode']}}: {{promo.promoCode}} {{promo.promoTitle}} {{promo.promoDescription}}. {{$productOrderCtrl.translations['antibody.pdp.commerceCard.promotion.learnmore']}}
产品信息
13452-1-AP
种属反应
宿主/亚型
分类
类型
抗原
偶联物
形式
浓度
规格
纯化类型
保存液
内含物
保存条件
运输条件
产品详细信息
Immunogen sequence: MCTVVDPRI VRRYLLRRQL GQGAYGIVWK AVDRRTGEVV AIKKIFDAFR DKTDAQRTFR EITLLQEFGD HPNIISLLDV IRAENDRDIY LVFEFMGCPP SPPPPTAVRT LSADTDLNAV IRKGGLLQDV HVRSIFYQLL RATRFLHSGH VVHRDQKPSN VLLDANCTVK LCDFGLARSL GDLPEGPEDQ AVTEYVATRW YRAPEVLLSS HRYTLGVDMW SLGCILGEML RGRPLFPGTS TLHQLELILE TIPPPSEEDL LALGSGCRAS VLHQL (1-274 aa encoded by BC028034)
靶标信息
The ERKs are a subfamily of the MAPKs that have been implicated in cell growth and differentiation. Extracellular signal-regulated kinase 8 (Erk8) is a large MAP kinase whose activity is controlled by serum and the c-Src non-receptor tyrosine kinase. ERK8 down-regulates transactivation of the glucocorticoid receptor through Hic-5 and can negatively regulate transcriptional co-activation of androgen receptor and GRalpha by Hic-5 in a kinase-independent manner, suggesting a broader role for ERK8 in the regulation of nuclear receptors beyond estrogen receptor alpha. Erk8 is a novel effector of RET/PTC3 and, therefore, RET biological functions.
仅用于科研。不用于诊断过程。未经明确授权不得转售。
生物信息学
蛋白别名: EC 2.7.11.24; ERK-7; ERK-8; ERK8 delta; protein kinase; MAP kinase family protein; extracellular regulated kinase 8 delta; Extracellular signal-regulated kinase 7; Extracellular signal-regulated kinase 8; MAP kinase 15; MAPK 15; Mitogen-activated protein kinase 15
基因别名: BC048082; ERK7; ERK8; MAPK15
UniProt ID: (Human) Q8TD08, (Rat) Q9Z2A6, (Mouse) Q80Y86
Entrez Gene ID: (Human) 225689, (Rat) 286997, (Mouse) 332110